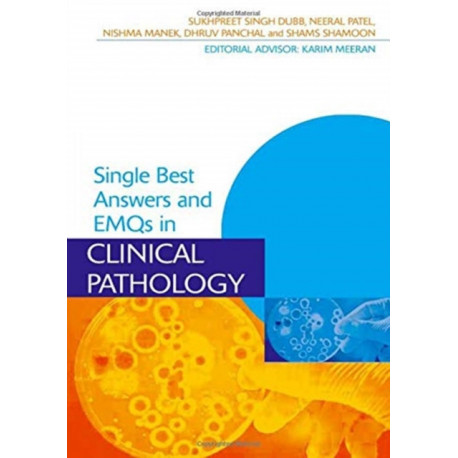
Single Best Answers and EMQs in Clinical Pathology

Kurv
Vare
varer
(tom)
Ingen varer
Fastlægges senere
Forsendelse
0,- kr
I alt
Single Best Answers and EMQs in Clinical Pathology
(Bog, Hardback, Engelsk)
Forlag:
Taylor & Francis Ltd
- Type: Bog
- Format: Hardback
-
Sprog:
Engelsk

- ISBN-13: 9781138456648
- Se flere detaljer ▼
Beskrivelse
This book presents 200 single best answer-style and 50 extended matching question-style questions arranged by sub-specialty area as well as a practice exam of random questions. It provides medical students with a useful source for exam revision as well as supplementing their knowledge.
Læsernes anmeldelser (0)
Alle detaljer
| Forlag | Taylor & Francis Ltd |
| Forfattere | Sukhpreet (MBBS BSc (Hons) FY1 Doctor Dubb, Neeral (MBBS BSc (Hons) Patel, Nishma (MBBS BSc (Hons) Manek, Dhruv (MBBS BSc (Hons) Panchal, Shams (BSc (Hons) Shamoon |
| Type | Bog |
| Format | Hardback |
| Sprog | Engelsk |
| Udgivelsesdato | 30-06-2017 |
| Første udgivelsesår | 2017 |
| Serie | Medical Finals Revision Series |
| Fagredaktør | Karim (Professor of Endocrinology Meeran |
| Originalsprog | United Kingdom |
| Sideantal | 408 |
| Indbinding | Hardback |
| Forlag | Taylor & Francis Ltd |
| Sideoplysninger | 408 pages |
| Mål | 234 x 156 |
| ISBN-13 / EAN-13 | 9781138456648 |

